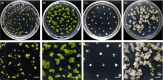
Figure 6

Application of protoplast technology to CRISPR/Cas9 mutagenesis: from single-cell mutation detection to mutant plant regeneration
- PMID: 29230929
- PMCID: PMC5999315
- DOI: 10.1111/pbi.12870
Application of protoplast technology to CRISPR/Cas9 mutagenesis: from single-cell mutation detection to mutant plant regeneration
Abstract
Plant protoplasts are useful for assessing the efficiency of clustered regularly interspaced short palindromic repeats (CRISPR)/CRISPR-associated protein 9 (Cas9) mutagenesis. We improved the process of protoplast isolation and transfection of several plant species. We also developed a method to isolate and regenerate single mutagenized Nicotianna tabacum protoplasts into mature plants. Following transfection of protoplasts with constructs encoding Cas9 and sgRNAs, target gene DNA could be amplified for further analysis to determine mutagenesis efficiency. We investigated N. tabacum protoplasts and derived regenerated plants for targeted mutagenesis of the phytoene desaturase (NtPDS) gene. Genotyping of albino regenerants indicated that all four NtPDS alleles were mutated in amphidiploid tobacco, and no Cas9 DNA could be detected in most regenerated plants.
Keywords: CRISPR/Cas9; protoplast isolation; protoplast regeneration; single-cell analysis.
© 2017 The Authors. Plant Biotechnology Journal published by Society for Experimental Biology and The Association of Applied Biologists and John Wiley & Sons Ltd.
Conflict of interest statement
The authors declare that they have no competing interests.
Figures

References
-
- Bortesi, L. and Fischer, R. (2015) The CRISPR/Cas9 system for plant genome editing and beyond. Biotechnol. Adv. 33, 41–52. - PubMed
-
- Brennecke, P. , Anders, S. , Kim, J.K. , Kolodziejczyk, A.A. , Zhang, X. , Proserpio, V. , Baying, B. et al. (2013) Accounting for technical noise in single‐cell RNA‐seq experiments. Nat. Methods, 10, 1093–1095. - PubMed
Publication types
MeSH terms
Substances
Associated data
- Actions
- Actions
LinkOut - more resources
Full Text Sources
Other Literature Sources

